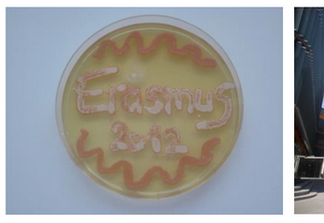
Dina Vorkapić – Moje ERASMUS iskustvo

Ana Martinović i Anita Ament – Naše ERASMUS iskustvo
Olomouc je grad u Češkoj Republici, smješten u istočnom dijelu na rijeci Moravi. Jedan je od najljepših gradova Češke, bogat srednjovjekovnom kulturom i poznat...
Iva Marković
Jedno od najljepših i najintenzivnijih perioda u mom životu do sada, bio je boravak u glavnom gradu Slovenije, Ljubljani u razdoblju od ožujka do...
Nikolina Bek
U sklopu ERASMUS+ programa boravila sam pet mjeseci tijekom akademske 2015./2016. godine u glavnom gradu Republike Austrije – Beču. Zimski semestar provela sam na...
Dina Vorkapić – Moje ERASMUS iskustvo
Ljetni semestar 2012. godine provela sam na Sveučilištu Karl-Franzens u Grazu u sklopu studijskog Erasmus programa, a u svrhu izrade svog diplomskog rada iz...
Mirna Velki – České Budějovice, Češka Republika
Od ožujka do lipnja 2010. u sklopu ERASMUS programa boravila sam u Češkoj Republici. Grad České Budějovice najveći je grad regije Južne Bohemije, te...
Moja Poljska avantura
Ponedjeljak 1. ožujka …. 8h upoznavanje mentorice i laboratorija u kojemu ću provesti većinu vremena tijekom razmjene!!! U laboratoriju za Aeropalinologiju odradit ću eksperimentalni...